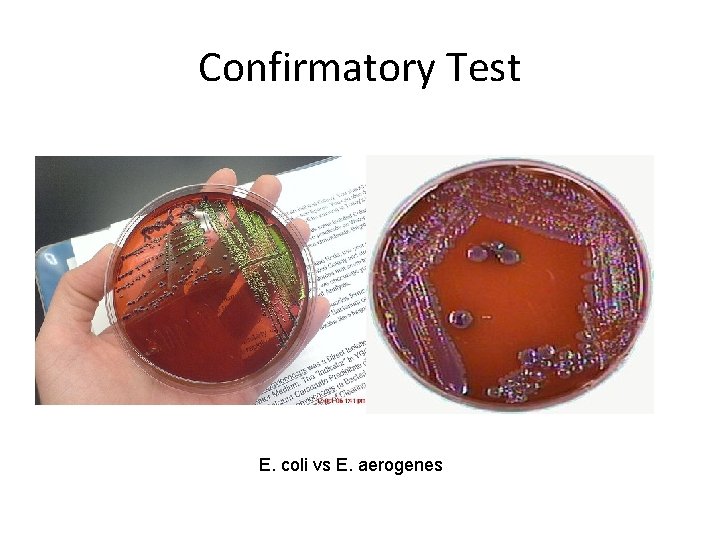
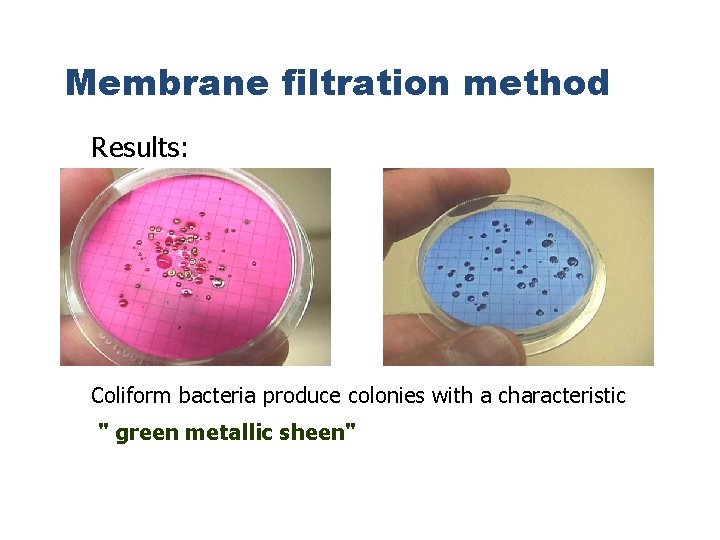

Practical 5 Water Microbiology I MPN test Introduction

Practical 5 Water Microbiology I MPN test

Introduction Water - Very essential factor needed by man (used for cooking, drinking, etc. ) -Open and widely accessible, making it susceptible to contamination by chemicals and bacterial pathogens -Once contaminated, it would be harmful for human consumption.

Water Borne Diseases • Are any illness caused by drinking water contaminated by human or animal faeces, which contain pathogenic microorganisms Prevalence: In developing countries, 4/5 of all the illnesses are caused by these, with diarrhea being the leading cause of childhood deaths.

Objectives 1. To perform the Most Probable Number (MPN) technique for testing the potability of different water samples. 2. To interpret results of water analyses using the MPN table. 3. To be familiar with common water-borne diseases and their causative agents.

Water Borne Diseases q. Bacterial infections - - Botulism Campylobacteriosis Cholera Chronic granulomatous disease Diarrheal disease due to E. coli. Dysentery - Shigella/Salmonella Legionellosis Leptospirosis Otitis externa- "Swimmer's Ear" Typhoid - Salmonella typhi bacteria q Viral infections • Hepatitis A: inflammation and necrosis of liver • Norwalk-type virus: acute gastroenteritis • Rotaviruses: acute gastroenteritis, especially in children • Enteroviruses: many types affect intestines and upper respiratory tract • Reoviruses: infects intestines and upper respiratory tract

Problems when testing water • Numerous water borne pathogens • Individual pathogen numbers may be too low to be detected in a reasonable sized water sample • Isolation and detection of some pathogens can take several days, weeks, or months • Absence of one particular pathogen does not rule out the presence of another.

Indicator Organism Concept • Widely used in determination and estimation of water contamination correlated to the presence of pathogens. • Why used: • Population large enough to isolate in small water samples (100 m. L) • Rapid • Inexpensive • Safe, not culturing pathogens

Bacterial-Indicator Organisms • Characteristics of a Useful Indicator • Useful for all water types • Always present when pathogens are present • Not present in the absence of the pathogen • Correlated with degree of pollution • More easily detectable than a pathogen • Survive longer than the pathogen • Not dangerous to work with • Common Groups • Coliforms( recent fecal contamination) Ø Total coliforms Ø Fecal coliforms Ø Escherichia coli • Streptococci Ø fecal streptococci Ø Enterococci • Spore Formers( indication of old fecal contamination) Ø Clostridium perfringens

Coliform Group (Total Coliform) • Enterobacteriaceae • Coliforms genera – Facultative anaerobe – Enterobacter – Gram negative – Klebsiella – Non-spore forming – Citrobacter – Rod shaped – Escherichia – Are commonly found – Ferment glucose contaminants in water. – Produce gas and acid – They share similar morphological , biochemical within 48 h at 35 C characteristics. – Ferment lactose

E. coli • E. coli are found in intestine, their ability to survive for brief periods outside the body makes them an ideal indicator organism to test environmental samples for fecal contamination. Indicator organisms indicate that water received contamination of intestinal origin. • E. coli are Gram negative bacterium that is commonly found in the lower intestine of warm-blooded animals, while other coliforms( Enterobacter, Klebsiella) can be found on plants and in soil.

Multiple Tube Fermentation Technique to determine Most Probable number • Uses a specified number of test tubes to statistically predict the number of organisms present (based on the expected population of organisms in the sample). • Tubes may also contain an inverted inner vial (Durham tube) for gas collection.

Multiple Tube Fermentation Methods • Specific dilution is made • Inoculate multiple tubes (3 or 5) of media with water sample • Incubate – 35 C or – 44. 5 C • Count positive growth tubes • Use Most-Probable-Number (MPN) table to estimate density

Methodology Sampling for Tap Water Samples 1 2 3 • Clean the tap. Let water flow for 1 -2 minutes. Sterilize tap with flame and collect sample Analyze water samples not more than 6 • hours after sampling or 24 hours if chilled. Multiple Tube Fermentation Technique •

Multiple Tube Fermentation Technique Presumptive Test Confirmatory Test Completed Test

Presumptive Test 1 Prepare and sterilize 3 Ds Mac broth(10 ml) with Durham • tubes, 6 Ss Mac broth ( 5 ml) with Durham tubes 2 Inoculation: first 3 tubes with 10 ml of the original • sample, next 3 with 1 ml of the original sample, next 3 with 0. 1 ml of the original sample. 3 Incubation for 35 -37 ˚C for 48 hours. Observe for gas • production, turbidity, and change in color to yellow. If positive proceed to Confirmatory Test.

Presumptive test

Confirmatory Test 1 BGLB tubes (10 ml ) with Durham tubes were prepared and • sterilized. Loopful of suspension from the positive presumptive tubes • was inoculated and incubated at 35°C for 48 hours. 2 EMB plate is inoculated and incubated at 35 C • Loopful of suspension was inoculated and incubated at 44 °C • for 24 hours. Sometimes an IMVi. C reaction is inoculated. • 3 BGBL : Turbidity and gas production is observed. • EMB: Green metallic sheen growth is observed on the plate. • IMVi. C reaction : ++-- • Those positive for the confirmatory test were subjected to the • completed test.

BGLB medium Peptone: a source of nitrogen, vitamins and minerals. Lactose: fermentable carbon source Ox gall (bile) and brilliant green: inhibitor of gram-positive bacteria and most gram-negative bacteria except coliforms Basic fuchsin and erioglaucine: p. H indicators Monopotassium phosphate: buffering agent 18
Confirmatory Test E. coli vs E. aerogenes

IMVi. C Test Indole + VP- MR+ Citrate -

Completed Test 1 • Representative colonies were chosen, • inoculated onto Lactose broth , and incubated for 35°C for 24 hours. ( Look for gas production) 2 • Perform gram-staining 3 Culture on NA slant •

Reading results • Presumptive test: • Any + ve tube is given a value of 1 • Any –ve tube is given a value of 0 • Add result of 3 tubes of 10 ml Ds Mac broth , then 3 tubes of 1 ml Ss Mac broth, then 3 tubes of 0. 1 ml Ss Mac broth • Get value of 3 Numbers e. g. 1 0 3 look it in MPN table , the index is 8 coliforms /100 ml of water. • If confirmed , then it should be reported.

10 m. L tubes Positive 23 MPN Table 1 -m. L tubes positive 0. 1 m. L tubes positive MPN/100 m. L 0 0 0 1 2 0 0 2 4 0 1 0 2 0 1 1 4 0 1 2 6 0 2 0 4 0 2 1 6 0 3 0 6 1 0 0 2 1 0 1 4 1 0 2 6 1 0 3 8 1 1 0 4 1 1 1 6 23

Directions for collection • Bottle is pre-sterilized. • Do not rinse bottle. It contains sodium thiosulfate to neutralize the bactericidal effect of chlorine. • When collecting tap water allow water to run or pumped out for several minutes to provide a representative sample from source. • Lake , river select a good place to obtain sample , and extend bottle away from body. • Best volume is 100 ml , 50 ml is OK. • The sample should be tested as soon as possible. If not possible it should be refrigerated until testing

Typical Water Quality Standards • Drinking and swimming pool water – No coliforms contamination acceptable less than 3 coliforms /100 ml of sample • Recreational water – 100 - 200 fecal coliforms /100 ml • Fish and wildlife habitat – 5000 fecal coliforms/100 ml

Practical 6 Water Microbiology II Membrane filtration method

Membrane Filter Methods • Filter water through a 0. 45 or 0. 47 μm membrane filter(Bacterial cells can not pass through) • Place membrane on selective media(EMB) • Incubate – 35 C total Coliform – 44. 5 C fecal Coliform • Count colonies

MF method

MF method Filter water through a 0. 45 μm membrane filter Place membrane on selective media Incubate 35 C total Coliform 44. 5 C fecal Coliform Count colonies
Membrane filtration method Results: Coliform bacteria produce colonies with a characteristic " green metallic sheen"

RESULTS • Quality limit: less than 1 Coliform /100 ml of water , the water is potable. • Action limit: 4 coliforms/100 ml of water, it means that the water company must take immediate action to remedy the problems that are responsible for the presence of coliforms in water.

Membrane filtration method Advantages – More than 100 ml samples can be tested – Effective and acceptable technique. Used to monitor drinking water in government laboratories. – Rapid – Lower chance of contamination – More accurate

MPN Advantages – It is relatively simple and cheap. – It is the method of choice for determining fecal coliforms densities and timing of contamination

Disadvantages MPN test M F method • Labor intensive • Not suitable for turbid Large amount of or waste waters. glassware is required • Its lack of precision, large errors • Still requires survival and culture of organisms in lab
- Slides: 34